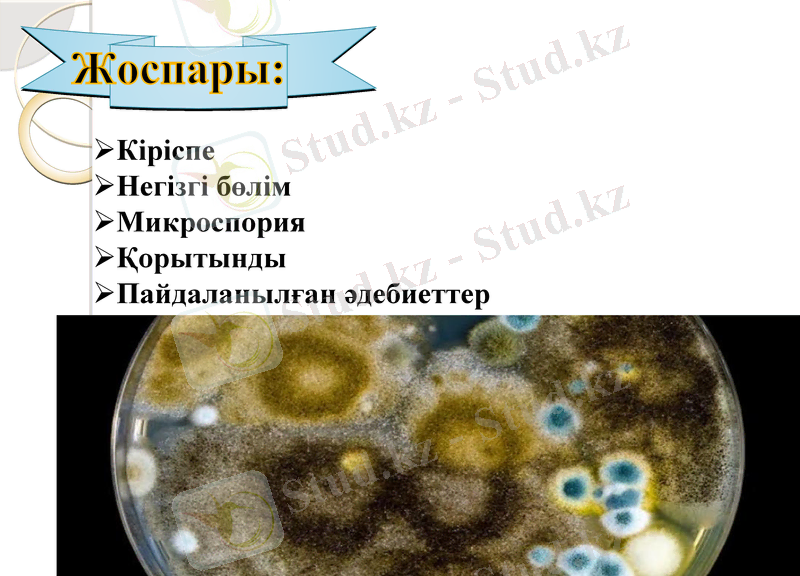
Slide 2

Жануарлардағы микроспория: қоздырғышы, эпизоотологиясы, клиникалық белгілері, диагностикасы және емі



Орындаған:Қапезқызы Б
Тобы:ВС-605
Тексерген:Омарбеков Е. О.
СӨЖ
Тақырыбы:Микроспория
Семей 2020 жыл
Жоспары:
Кіріспе
Негізгі бөлім
Микроспория
Қорытынды
Пайдаланылған әдебиеттер

Кіріспе
Микроспория (көне грекше: μικρός - кішкентай және көне грекше: σπόρος - дән) - тері мен шаштың ең кең таралған, саңырауқұлақтық және өте жұқпалы ауруларының бірі.


Микроспория (Microsporia, микроспороз) - жануарлардың, иттердің, аңдардың және жылқылардың созылмалы високонтагиозды саңырауқұлақ ауруы, ол терінің ұяшық қабыну қабыну және оның зақымдалған учаскелерінде, кейде тырнақтардың сынуы сипатталады. Аурулар әлемнің барлық елдерінде тіркеледі. Микроспориямен адам да ауырады.

Ауру қоздырғышы - Microsporum текті патогенді саңырауқұлақтар: атында - м. eguinum, иттерде, мысықтарда, кролдарда, шошқаларда, аңдар мен жыртқыш аңдарда, теңіз шошқаларында, бұғыларда, маймылдарда - М. lanosum (m. canis, m. pelineum), мысықтарда, иттерде, аттарда, бұзауларда, теңіз шошқаларында, шурів, тышқандарда - м. gypseum (Achorion gypseum, m. lanosum Bodin), шошқа-m. Nanum. Микроспорумның патологиялық материалында септелген мицелия және диаметрі 2-3 мкм дөңгелек бір клеткалы дау түрінде зақымданған шаш ішінде болады, бұл шаштың сыртқы жағының негізі жанында қаптама түрінде мозаикалы орналастырылады. Eguinum ортада тығыз орналасқан және сұр - ақ ауа мицелиймен жабылған қатпарлы, сұр-сары колониялар түрінде себуден кейін 6-7-ші портқа байқалады. Колонияларды микроскопиялық зерттеу кезінде мицелияның тармақталған септденуі, өлшемдегі жалғыз алмұрт тәрізді көп камералы микросконидиялар (1 . . . 2) х х (3 . . . 5) мкм. Көп клеткалы макроконидиялар, сопақ немесе веретен тәріздес пішінді, өлшемі (5 . . . 8) х х (15 . . . 35) мкм. Хламидоспори сирек терминалды. Г. lanosum 3-5-ші рет егуден кейін қойыртпақ шеңбермен дөңгелек сұр-ақ немесе сары колония түзеді, олар борпылдақ мицелиймен стеляды. Колонияларды микроскопиялық зерттеу кезінде мицелийдің тармақталған септденуі, сондай-ақ көлемі (1 . . . 3) х (1, 5 . . . 5, 0) сопақ-алмұрт тәрізді нысаны бар мкм.

Аурудың эпизоотологиясы. Микроспорияға көбінесе мысықтар, иттер, жылқы, теріден жасалған аңдар, сынықтар; сирек - Қойлар, ешкілер, шошқалар, бұғы, маймылдар, теңіз шошқалары, щуралар, тышқандар, жыртқыш аңдар ауырады. Микроспорозға сезімтал жас жануарлар. Инфекция қоздырғышының көзі ауру жануарлар мен тасымалдаушылар болып табылады, олар құрғағаннан кейін зақымдалған шаштары мен тері қабыршақтары бар қоздырғышты бөліп, қоршаған орта заттарын ұзақ уақыт контаминациялайды. Әсіресе, епизоотиялық ұяшықты ұстап тұруға қауіпті үйсіз мысықтар мен иттер, сондай-ақ кеміргіштер бар. gypseum. Жұқтыру ауру жануарлар дені сау болған жағдайда, сондай-ақ инфекцияланған азықтар, су, төсеніш, күтім заттары, қызмет көрсететін персоналдың киімі мен аяқ киімі арқылы жалпы ұсталынады. Иттер мен мысықтар жалаңаш, қаптау және сору кезінде инфекцияланады.

Патогенез. Эпидермистің мүйіз қабатындағы саңырауқұлақ дамуының салдарынан терінің үстіңгі қабыну және қышынуы, құрғақ және оңай сынатын шаш қоректенуінің бұзылуы пайда болады. Әртүрлі өлшемдегі және формадағы шектеулі шашсыз тері учаскелері пайда болады.

Аурудың клиникалық белгілері мен ағымы. Инкубациялық кезең 22-47 тәулікке созылады. Аурудың беттік, терең, қауырт және жасырын түрлері бар. Иттер мен мысықтарда аурудың жасырын түрі тіркеледі, кейде беттік. Шаштың зақымдану ауруының жасырын түрінде тек люминесценттік және микроскопиялық зерттеу арқылы ғана көрінуге болады. Беттік нысаны жиі котятта болады. Клиникалық тексеру кезінде лап, тұмсық, құйрық терісінде дөңгелек пішінді дақтар, кейде ақшыл-сұр қысқа шаштары бар, олар оңай сындырады. Кейбір учаскелерде терінің толық әлсіздігі байқалады. Иттерде көптеген зақымдау ұяшықтары мұзда, Арқада, денеде, сирек - табанда байқалады.

Тері аңдарында Микроспория жасырын нысаны бар және тек люминесценттік әдіспен көрсетіледі. Күшіктерде көздің айналасында, құлақтың негізі жанында, маңдайда, алдыңғы және артқы табандарда ұсақ көпіршіктері мен сұр-сары қабықтары бар дақтар байқалады. Жылқының зақымдануы, мойынның, жауырынның, Арқаның, жарманың, кейде ұшының учаскесінде оқшауланады. Жиі аурудың беттік түрі байқалады, ол диаметрі 3-4 см әр түрлі түрдегі шашсыз дақтардың пайда болуымен, терінің жоғарғы қабаттарына жақын шаш сынуымен, тесіктің болмауымен сипатталады. Кезде терең түрде дамуда анық айқын қабыну процессі, білім, тері корок бірі засохшего ексудату, әр түрлі өлшемді және пішінді дақтарды обломанным шашты. Атиптік формада терінің бұдырсыз учаскелері, терінің үстіңгі қабатының ұяшықты сіленуі көрсетіледі. Торай Зеңді зақымданулары мойынға, арқаға, жақтарында. Көбінесе терең пішін байқалады, ол сопақша, күрт шектелген қызыл дақтардың пайда болуымен көрінедіТүсті, кей жерлерде жағылған қоңыр кескіш қабықтармен біркелкі тегістеледі, қылшықты.


Зертханалық диагностика. Люминесцентті және микроскопиялық зерттеу әдістерін қамтиды. Зертханаға тығыны бар пробиркалардағы немесе кішкене целлофан пакеттердегі шаштар, қабыршықтар, қыртыстар, сондай-ақ терінің әр түрлі зақымданған бөліктерінен алынған қыртыстар жіберіледі. Люминесцентті әдіс ауру жануарлардың түкті қабатын немесе зақымдалған шашты қараңғыланған үй-жайда зерттеуді қарастырады, ол кезде микроспорумдармен зақымдалған шашты ерекше изумрудно-жасыл шам көрсетеді. Трихофитияда шаш шамдары байқалмайды. Сондай-ақ, қара түсті жануарлардың шашының Микроспория саңырауқұлақ зақымдаған. Ультракүлгін сәуле көзі ретінде спектрдің көрінетін бөлігін кідіртуге және ультракүлгін өткізуге қабілетті жарық сүзгілері бар сынап-кварц шамдарын пайдаланады. Зерттеу жануарларды әртүрлі препараттармен емдейді, өйткені олардың кейбіреулері (салицил қышқылы, риванол, вазелин және т. б. ) флуоресцацияланады.

Дифференциалдық диагностика. Микроспорияны трихофития мен қышымадан ажырату қажеттілігін қарастырады. Трихофитияда жылқыда күшті тесік байқалады және люминесцентті тексеру кезінде зақымдалған шашты жарқылдамайды. Микроскопиямен шаштың ішінде қалқаншасы бар гифтердің дұрыс қатарларын, шашта және оның негізінің жанында үлкен дау тізбектерін анықтайды. Қышыма кезінде әрдайым қатты тесік байқалады, микроскопия кенелерді анықтайды.

- Іс жүргізу
- Автоматтандыру, Техника
- Алғашқы әскери дайындық
- Астрономия
- Ауыл шаруашылығы
- Банк ісі
- Бизнесті бағалау
- Биология
- Бухгалтерлік іс
- Валеология
- Ветеринария
- География
- Геология, Геофизика, Геодезия
- Дін
- Ет, сүт, шарап өнімдері
- Жалпы тарих
- Жер кадастрі, Жылжымайтын мүлік
- Журналистика
- Информатика
- Кеден ісі
- Маркетинг
- Математика, Геометрия
- Медицина
- Мемлекеттік басқару
- Менеджмент
- Мұнай, Газ
- Мұрағат ісі
- Мәдениеттану
- ОБЖ (Основы безопасности жизнедеятельности)
- Педагогика
- Полиграфия
- Психология
- Салық
- Саясаттану
- Сақтандыру
- Сертификаттау, стандарттау
- Социология, Демография
- Спорт
- Статистика
- Тілтану, Филология
- Тарихи тұлғалар
- Тау-кен ісі
- Транспорт
- Туризм
- Физика
- Философия
- Халықаралық қатынастар
- Химия
- Экология, Қоршаған ортаны қорғау
- Экономика
- Экономикалық география
- Электротехника
- Қазақстан тарихы
- Қаржы
- Құрылыс
- Құқық, Криминалистика
- Әдебиет
- Өнер, музыка
- Өнеркәсіп, Өндіріс
Қазақ тілінде жазылған рефераттар, курстық жұмыстар, дипломдық жұмыстар бойынша біздің қор #1 болып табылады.



Ақпарат
Қосымша
Email: info@stud.kz